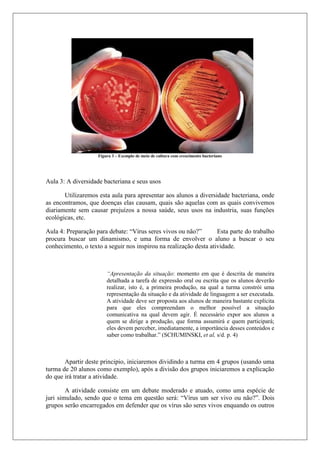
Figura 3 – Exemplo de meio de cultura com crescimento bacteriano
Aula 3: A diversidade bacteriana e seus usos
Utilizaremos esta aula para apresentar aos alunos a diversidade bacteriana, onde
as encontramos, que doenças elas causam, quais são aquelas com as quais convivemos
diariamente sem causar prejuízos a nossa saúde, seus usos na industria, suas funções
ecológicas, etc.
Aula 4: Preparação para debate: “Vírus seres vivos ou não?” Esta parte do trabalho
procura buscar um dinamismo, e uma forma de envolver o aluno a buscar o seu
conhecimento, o texto a seguir nos inspirou na realização desta atividade.
“Apresentação da situação: momento em que é descrita de maneira
detalhada a tarefa de expressão oral ou escrita que os alunos deverão
realizar, isto é, a primeira produção, na qual a turma constrói uma
representação da situação e da atividade de linguagem a ser executada.
A atividade deve ser proposta aos alunos de maneira bastante explícita
para que eles compreendam o melhor possível a situação
comunicativa na qual devem agir. É necessário expor aos alunos a
quem se dirige a produção, que forma assumirá e quem participará;
eles devem perceber, imediatamente, a importância desses conteúdos e
saber como trabalhar.” (SCHUMINSKI, et al, s/d. p. 4)
Apartir deste principio, iniciaremos dividindo a turma em 4 grupos (usando uma
turma de 20 alunos como exemplo), após a divisão dos grupos iniciaremos a explicação
do que irá tratar a atividade.
A atividade consiste em um debate moderado e atuado, como uma espécie de
juri simulado, sendo que o tema em questão será: “Vírus um ser vivo ou não?”. Dois
grupos serão encarregados em defender que os vírus são seres vivos enquando os outros

O documento discute as concepções prévias de estudantes sobre vírus e bactérias, identificando confusões comuns entre os dois tipos de microrganismos. Uma proposta didática é desenvolvida com base nos resultados, com o objetivo de melhorar a compreensão dos alunos sobre a diferenciação entre vírus e bactérias.